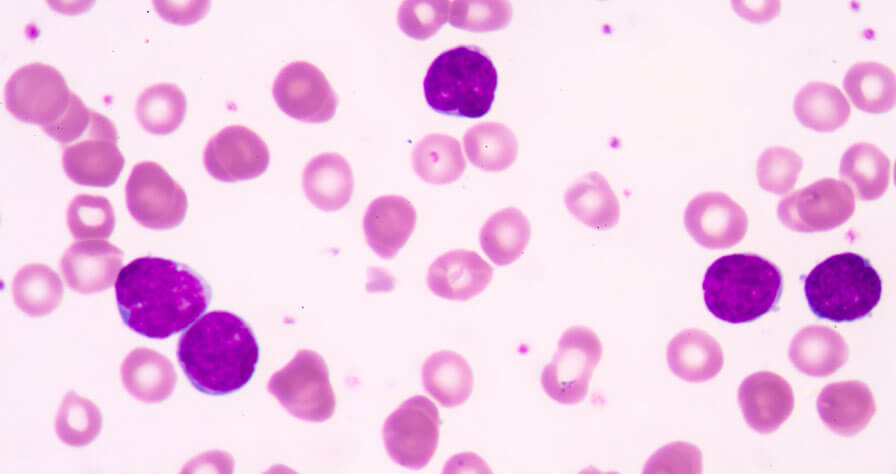

Take Three Minutes to Learn About Leukemia

Approximately every three minutes, someone in the U.S. is diagnosed with a blood cancer. Among the most common blood cancers is leukemia. Leukemia causes rapid production of abnormal white blood cells in your body. These abnormal white blood cells are not able to fight infection and impair the ability of your bone marrow to produce red blood cells and platelets. Leukemia is usually described as being either acute (fast growing) or chronic (slow growing).
Although experts are uncertain about the causes of leukemia, they have identified several risk factors that include the following:
- Exposure to high levels of radiation
- Repeated exposure to certain chemicals such as benzene. Benzene is found in car exhaust, as well as cigarette smoke.
- Chemotherapy
- Down Syndrome and other genetic diseases
- A strong family history of leukemia
Symptoms of leukemia can include the following:
- Fever, chills, night sweats and other flu-like symptoms
- Weakness and fatigue
- Swollen or bleeding gums
- Headaches
- Enlarged liver and spleen
- Swollen tonsils
- Bone pain
- Paleness
- Pinhead-size red spots on the skin
- Weight loss
Because the cause of leukemia remains unknown, there is no certain way to prevent the disease. However, there are some preventive measures that you can take:
- Live a healthy lifestyle. Eat plenty of green leafy vegetables and fruits. Avoid or reduce the amount of red meat you eat. Exercise regularly and get plenty of rest.
- Avoid or stop smoking. Smoking increases your risk of getting leukemia by 30 percent.
- Minimize your exposure to radiation, herbicides, and insecticides. If you’re concerned about any products in your home, contact a professional for an inspection.
Quick facts. There are more than 310,000 people living with, or in remission from, leukemia in the U.S. Leukemia is the fifth leading cause of cancer-related death among men; among women, it is the seventh.